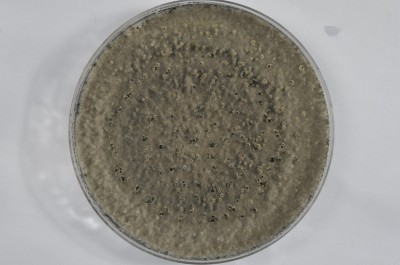
Forzaspal -COLLETOTRICHUM_olivo_frutto_875-sfr_PDA_10gg_capsula_petri.JPG (235.87 KiB) Osservato 594 volte Forzaspal -COLLETOTRICHUM_olivo_frutto_875-sfr_PDA_10gg_capsula_petri.JPG

Gli isolamenti hanno prodotto colonie.
Premetto che i patogeni in grado di provocare marciumi sono diversi e in particolare quello che causa la c.d. antracnosi o lebbra delle olive è data presente da noi in due tipi (
Colletrotichum gloeosporioides,
C. acutatum), il secondo più aggressivo mentre il primo è il classico che si manifesta ordinariamente in autunno. La sistematica di questi funghi è complessa e per andare oltre occorrerebbe indagini sul DNA.
In condizioni ambientali idonee producono sulle tacche delle olive colpite dei corpi fruttiferi detti
acervuli che emettono masserelle di conidi, la cui forma differisce nei due tipi (nel secondo hanno le estremità tendenzialmente appuntite).
Su terreni di coltura le colonie normalmente manifestano una tipica colorazione rosa-aranciata e producono corpiccioli (
conidiomata) che emettono i conidi.
In questo momento un laboratorio ci sono due isolamenti, uno dei campioni inviatimi dal Forzaspal, e un secondo proveniente dalla zona di Ivrea (quella del post di Beps, ma non sono sue olive). In corso c'è una terza diagnosi su olive che ho raccolto la settimana scorsa al mare da ulivi che ho in giardino e che quest'anno presentano una forte presenza di olive intaccate: dall'osservazione diretta ho potuto constatare che in parecchi casi il marciume si è manifestato a seguito di attacchi di mosca, in altri invece è primario.
Mostrerò foto relative ai tre casi.
Olive Forzaspal:
1) aspetto delle olive
2) acervuli su frutto
3) aspetto della colonia
4) aspetto dei conidi
- Allegati
-

-

-

-